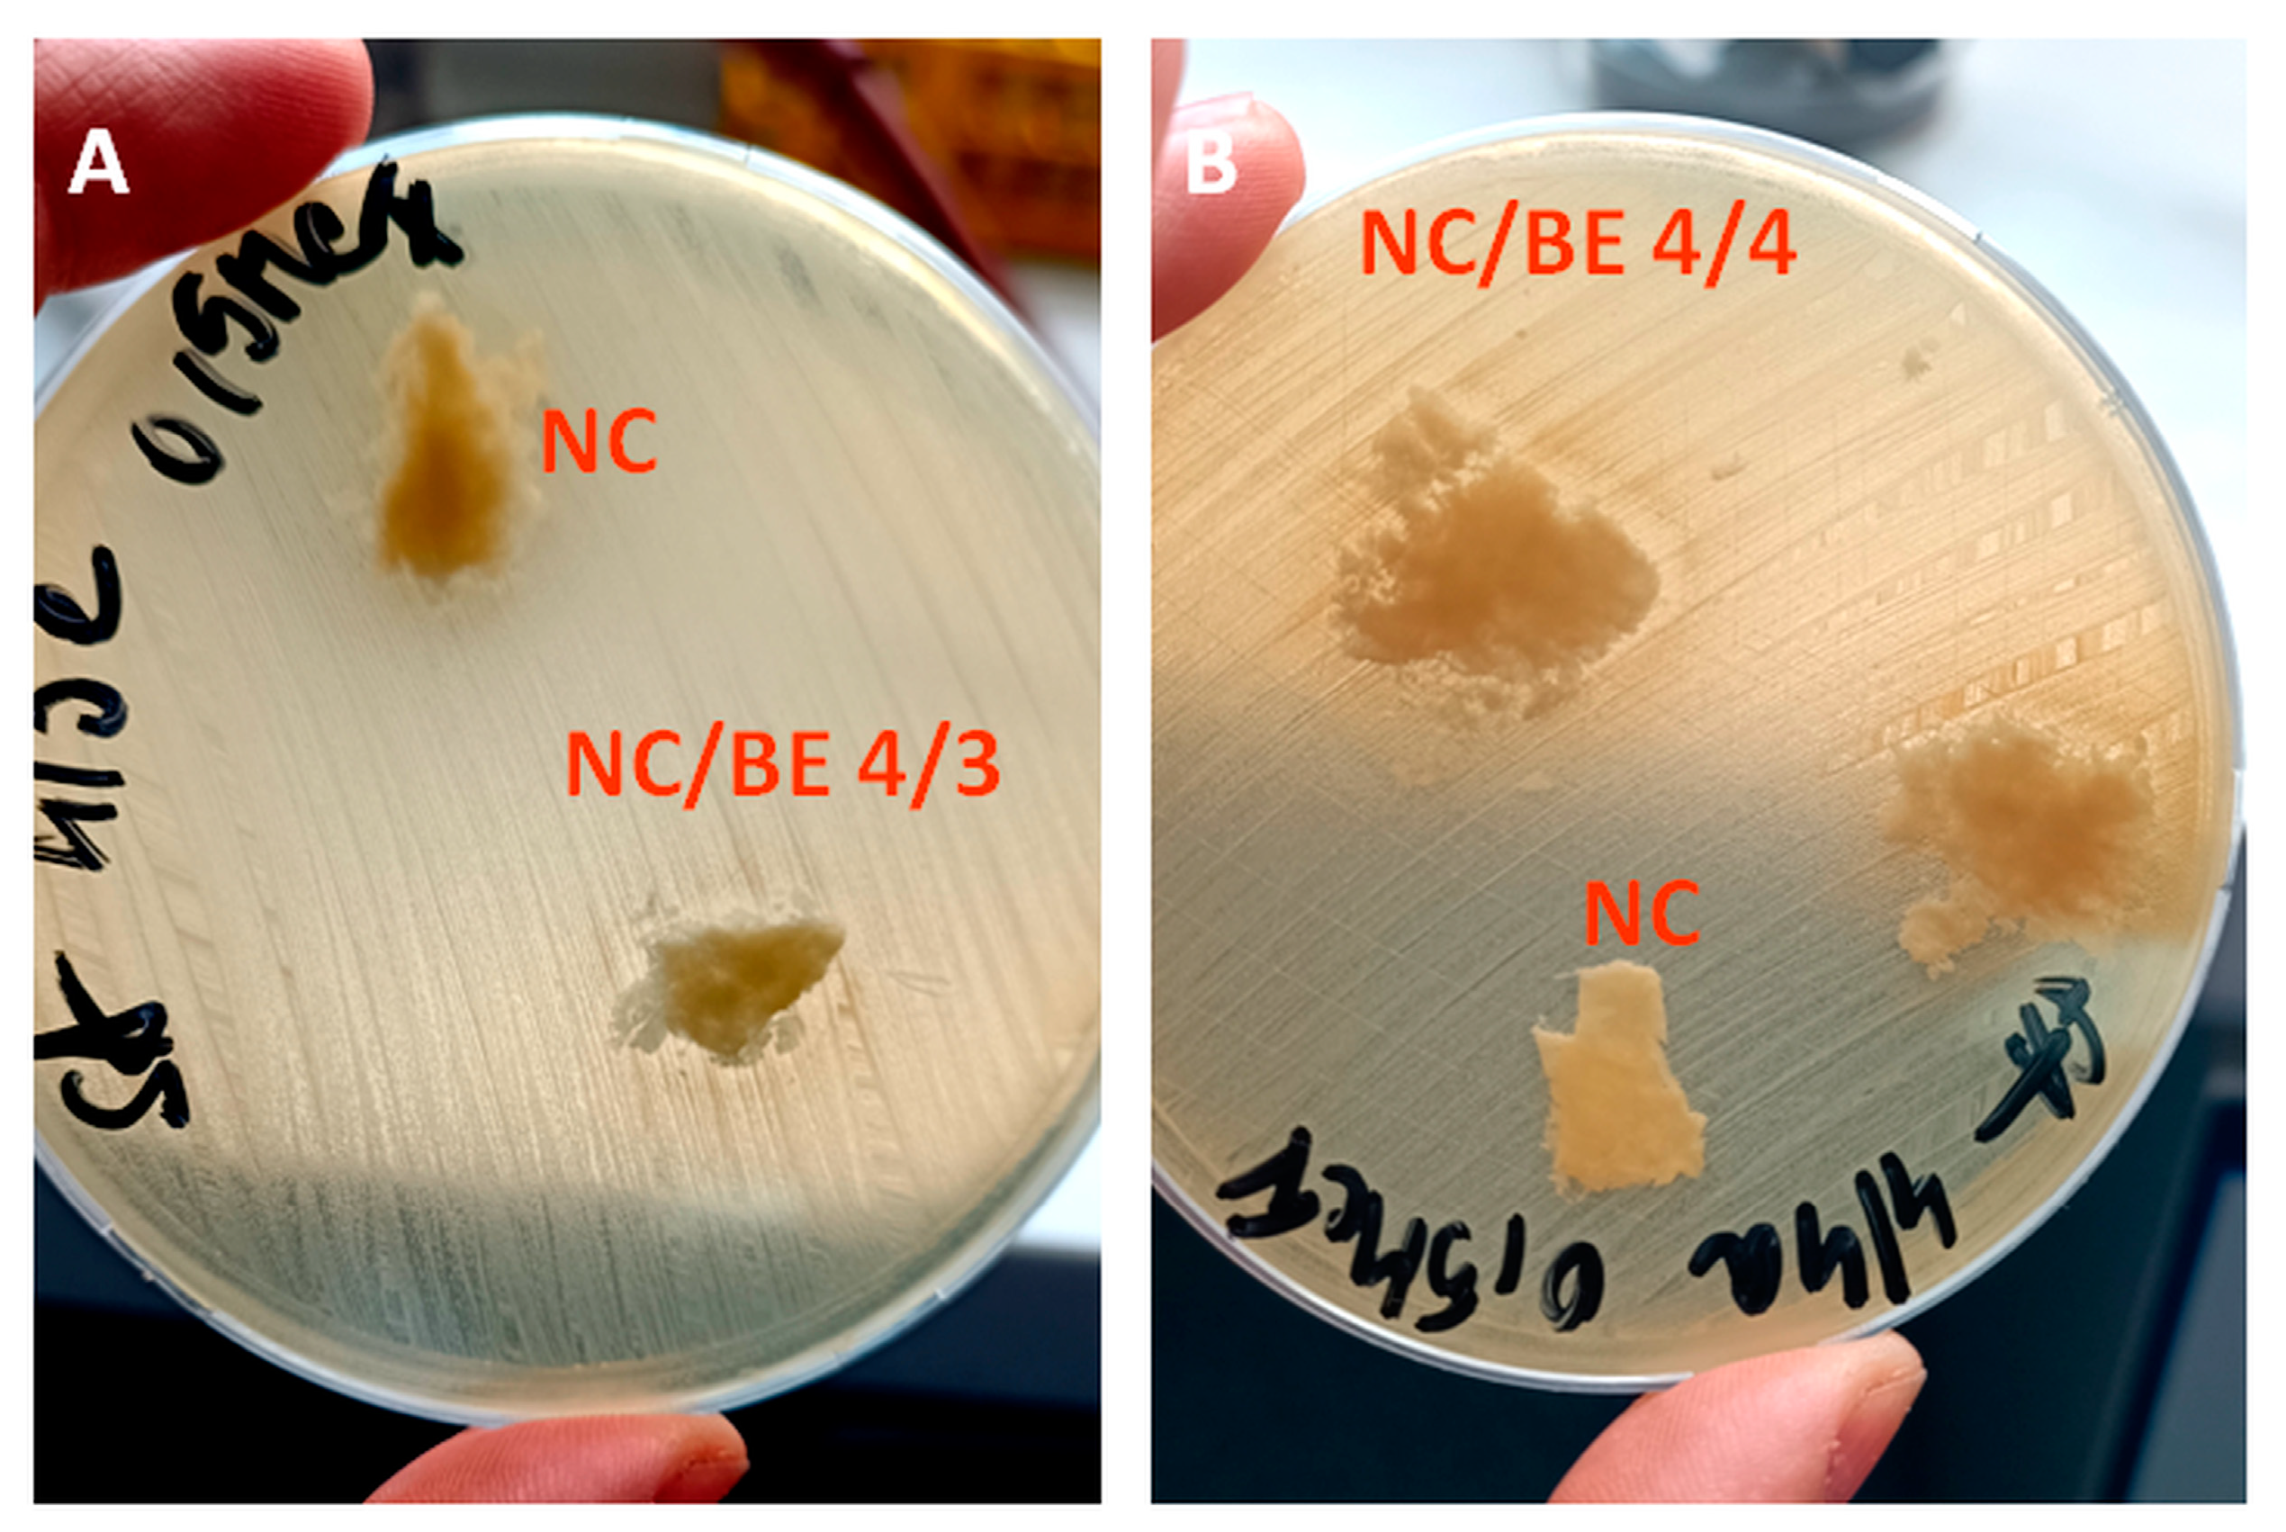
Ijms 24 11871 g010

Nanocellulose Sponges Containing Antibacterial Basil Extract
Abstract
1. Introduction
2. Results
2.1. FT-IR Spectroscopy Analysis
2.2. Thermogravimetric Analysis (TGA)
2.3. Scanning Electron Microscopy (SEM) Analysis
2.4. Microcomputer Tomography (Micro-CT)
2.5. Dynamic Mechanical Analysis (DMA)
2.6. X-ray Diffraction (XRD)
2.7. Antibacterial Activity
2.8. Cytotoxicity Tests
3. Materials and Methods
3.1. Materials
3.2. Basil Seed Mucilage (BSM) Extraction
3.3. Preparation of Nanocellulose Sponges
3.4. Characterization
3.4.1. Fourier-Transform Infrared Spectroscopy (FT-IR) Spectroscopy
3.4.2. Thermogravimetric Analysis (TGA)
3.4.3. Scanning Electron Microscopy (SEM)
3.4.4. Microcomputer Tomography (Micro-CT)
3.4.5. Dynamic Mechanical Analysis (DMA)
3.4.6. X-ray Diffraction (XRD)
3.4.7. Antibacterial Activity
3.4.8. Cytotoxicity Tests
4. Conclusions
Supplementary Materials
Author Contributions
Funding
Informed Consent Statement
Data Availability Statement
Acknowledgments
Conflicts of Interest
References
- Rana, A.K.; Mostafavi, E.; Alsanie, W.F.; Siwal, S.S.; Thakur, V.K. Cellulose-based materials for air purification: A review. Ind. Crops Prod. 2023, 194, 116331. [Google Scholar] [CrossRef]
- Carvalho, J.P.F.; Silva, A.C.Q.; Bastos, V.; Oliveira, H.; Pinto, R.J.B.; Silvestre, A.J.D.; Vilela, C.; Freire, C.S.R. Nanocellulose-Based Patches Loaded with Hyaluronic Acid and Diclofenac towards Aphthous Stomatitis Treatment. Nanomaterials 2020, 10, 628. [Google Scholar] [CrossRef] [PubMed]
- Li, J.; Cha, R.; Mou, K.; Zhao, X.; Long, K.; Luo, H.; Zhou, F.; Jiang, X. Nanocellulose-Based Antibacterial Materials. Adv. Healthc. Mater. 2018, 20, e1800334. [Google Scholar] [CrossRef] [PubMed]
- Frone, A.N.; Panaitescu, D.M.; Chiulan, I.; Nicolae, C.A.; Casarica, A.; Gabor, A.R.; Trusca, R.; Damian, C.M.; Purcar, V.; Alexandrescu, E.; et al. Surface Treatment of Bacterial Cellulose in Mild, Eco-Friendly Conditions. Coatings 2018, 8, 221. [Google Scholar] [CrossRef]
- Usurelu, C.D.; Badila, S.; Frone, A.N.; Panaitescu, D.M. Poly(3-hydroxybutyrate) Nanocomposites with Cellulose Nanocrystals. Polymers 2022, 14, 1974. [Google Scholar] [CrossRef]
- Fonseca, D.F.S.; Carvalho, J.P.F.; Bastos, V.; Oliveira, H.; Moreirinha, C.; Almeida, A.; Silvestre, A.J.D.; Vilela, C.; Freire, C.S.R. Antibacterial Multi-Layered Nanocellulose-Based Patches Loaded with Dexpanthenol for Wound Healing Applications. Nanomaterials 2020, 10, 2469. [Google Scholar] [CrossRef] [PubMed]
- Panaitescu, D.M.; Stoian, S.; Frone, A.N.; Vlăsceanu, G.M.; Baciu, D.D.; Gabor, A.R.; Nicolae, C.A.; Radiţoiu, V.; Alexandrescu, E.; Căşărică, A.; et al. Nanofibrous scaffolds based on bacterial cellulose crosslinked with oxidized sucrose. Int. J. Biol. Macromol. 2022, 221, 381–397. [Google Scholar] [CrossRef]
- Si, Y.; Lin, Q.; Zhou, F.; Qing, J.; Luo, H.; Zhang, C.; Zhang, J.; Cha, R. The interaction between nanocellulose and microorganisms for new degradable packaging: A review. Carbohydr. Polym. 2022, 295, 119899. [Google Scholar] [CrossRef]
- Oprea, M.; Panaitescu, D.M. Nanocellulose Hybrids with Metal Oxides Nanoparticles for Biomedical Applications. Molecules 2020, 25, 4045. [Google Scholar] [CrossRef]
- Ahankari, S.S.; Subhedar, A.R.; Bhadauria, S.S.; Dufresne, A. Nanocellulose in food packaging: A review. Carbohydr. Polym. 2021, 255, 117479. [Google Scholar] [CrossRef]
- Barua, S.; Das, G.; Aidew, L.; Buragohain, A.K.; Karak, N. Copper-copper oxide coated nanofibrillar cellulose: A promising biomaterial. RSC Adv. 2013, 3, 14997–15004. [Google Scholar] [CrossRef]
- Wahid, F.; Duan, Y.; Hu, X.; Chu, L.; Jia, S.; Cui, J.; Zhong, C. A facile construction of bacterial cellulose/ZnO nanocomposite films and their photocatalytic and antibacterial properties. Int. J. Biol. Macromol. 2019, 132, 692–700. [Google Scholar] [CrossRef]
- Panaitescu, D.M.; Ionita, E.R.; Nicolae, C.-A.; Gabor, A.R.; Ionita, M.D.; Trusca, R.; Lixandru, B.-E.; Codita, I.; Dinescu, G. Poly(3-hydroxybutyrate) Modified by Nanocellulose and Plasma Treatment for Packaging Applications. Polymers 2018, 10, 1249. [Google Scholar] [CrossRef]
- El-Wakil, N.A.; Hassan, E.A.; Abou-Zeid, R.E.; Dufresne, A. Development of wheat gluten/nanocellulose/titanium dioxide nanocomposites for active food packaging. Carbohydr. Polym. 2015, 124, 337–346. [Google Scholar] [CrossRef]
- Wang, S.; Sun, J.; Jia, Y.; Yang, L.; Wang, N.; Xianyu, Y.; Chen, W.; Li, X.; Cha, R.; Jiang, X. Nanocrystalline Cellulose-Assisted Generation of Silver Nanoparticles for Nonenzymatic Glucose Detection and Antibacterial Agent. Biomacromolecules 2016, 17, 2472–2478. [Google Scholar] [CrossRef] [PubMed]
- Yenn, T.W.; bin Abdullah, A.Y.K.; Rozman, N.A.S.; bin Wahid, M.I.A.; Hossain, M.S.; Leomg, C.R.; Lazim, Y.; Tan, W.-N. Antimicrobial wound dressing film utilizing cellulose nanocrystal as drug delivery system for curcumin. Cellulose 2018, 25, 631–638. [Google Scholar] [CrossRef]
- Sabio, L.; González, A.; Ramírez-Rodríguez, G.B.; Gutiérrez-Fernández, J.; Bañuelo, O.; Olivares, M.; Gálvez, N.; Delgado-López, J.M.; Dominguez-Vera, J.M. Probiotic cellulose: Antibiotic-free biomaterials with enhanced antibacterial activity. Acta Biomater. 2021, 124, 244–253. [Google Scholar] [CrossRef]
- Taokaew, S.; Chiaoprakobkij, N.; Siripong, P.; Sanchavanakit, N.; Pavasant, P.; Phisalaphong, M. Multifunctional cellulosic nanofiber film with enhanced antimicrobial and anticancer properties by incorporation of ethanolic extract of Garcinia mangostana peel. Mater. Sci. Eng. C Mater. Biol. Appl. 2021, 120, 111783. [Google Scholar] [CrossRef]
- Lodhi, B.A.; Hussain, M.A.; Ashraf, M.U.; Haseeb, M.T.; Muhammad, G.; Farid-ul-Haq, M.; Naeem-ul-Hassan, M. Basil (Ocimum basilicum L.) seeds engender a smart material for intelligent drug delivery: On-Off switching and real-time swelling, in vivo transit detection, and mechanistic studies. Ind. Crops Prod. 2020, 155, 112780. [Google Scholar] [CrossRef]
- Chowdhary, K.; Kumar, A.; Sharma, S.; Pathak, R.; Jangir, M. Ocimum sp.: Source of biorational pesticides. Ind. Crops Prod. 2018, 122, 686–701. [Google Scholar] [CrossRef]
- Stan, C.; Nenciu, F.; Muscalu, A.; Vlăduț, V.N.; Burnichi, F.; Popescu, C.; Gatea, F.; Boiu-Sicuia, O.A.; Israel-Roming, F. Chemical Composition, Antioxidant and Antimicrobial Effects of Essential Oils Extracted from Two New Ocimum basilicum L. Varieties. Diversity 2022, 14, 1048. [Google Scholar] [CrossRef]
- Tsasi, G.; Mailis, T.; Daskalaki, A.; Sakadani, E.; Razis, P.; Samaras, Y.; Skaltsa, H. The Effect of Harvesting on the Composition of Essential Oils from Five Varieties of Ocimum basilicum L. Cultivated in the Island of Kefalonia, Greece. Plants 2017, 6, 41. [Google Scholar] [CrossRef] [PubMed]
- Prinsi, B.; Morgutti, S.; Negrini, N.; Faoro, F.; Espen, L. Insight into Composition of Bioactive Phenolic Compounds in Leaves and Flowers of Green and Purple Basil. Plants 2019, 9, 22. [Google Scholar] [CrossRef] [PubMed]
- Singh, S.; Gaikwad, K.K.; Lee, Y.S. Antimicrobial and antioxidant properties of polyvinyl alcohol bio composite films containing seaweed extracted cellulose nano-crystal and basil leaves extract. Int. J. Biol. Macromol. 2018, 107 Pt B, 1879–1887. [Google Scholar] [CrossRef]
- Mishra, D.; Khare, P.; Singh, D.K.; Yadav, V.; Luqman, S.; Kumar, P.A.; Shanker, K. Synthesis of Ocimum extract encapsulated cellulose nanofiber/chitosan composite for improved antioxidant and antibacterial activities. Carbohydr. Polym. Technol. Appl. 2021, 2, 100152. [Google Scholar] [CrossRef]
- Halimatuddahliana, N.; Wijaya, F.; Mitro, E. Characteristics of CNC reinforced cassava starch biocomposites activated with holy basil extract. AIP Conf. Proc. 2020, 2267, 020038. [Google Scholar] [CrossRef]
- Chaudhary, N.; Mishra, G.; Yadav, T.; Srivastava, N.; Maurya, V.K.; Saxena, S.K. Fabrication and Evaluation of Basil Essential Oil-Loaded Halloysite Nanotubes in Chitosan Nanocomposite Film and Its Application in Food Packaging. Antibiotics 2022, 11, 1820. [Google Scholar] [CrossRef]
- Giannakas, A.E.; Salmas, C.E.; Leontiou, A.; Baikousi, M.; Moschovas, D.; Asimakopoulos, G.; Zafeiropoulos, N.E.; Avgeropoulos, A. Synthesis of a Novel Chitosan/Basil Oil Blend and Development of Novel Low Density Poly Ethylene/Chitosan/Basil Oil Active Packaging Films Following a Melt-Extrusion Process for Enhancing Chicken Breast Fillets Shelf-Life. Molecules 2021, 26, 1585. [Google Scholar] [CrossRef]
- Amor, G.; Sabbah, M.; Caputo, L.; Idbella, M.; De Feo, V.; Porta, R.; Fechtali, T.; Mauriello, G. Basil Essential Oil: Composition, Antimicrobial Properties, and Microencapsulation to Produce Active Chitosan Films for Food Packaging. Foods 2021, 10, 121. [Google Scholar] [CrossRef]
- Mortazavi Moghadam, F.A.; Khoshkalampour, A.; Mortazavi Moghadam, F.A.; PourvatanDoust, S.; Naeijian, F.; Ghorbani, M. Preparation and physicochemical evaluation of casein/basil seed gum film integrated with guar gum/gelatin based nanogel containing lemon peel essential oil for active food packaging application. Int. J. Biol. Macromol. 2023, 224, 786–796. [Google Scholar] [CrossRef]
- Biglarian, N.; Rafe, A.; Shahidi, A. Effect of basil seed gum and κ-carrageenan on the rheological, textural, and structural properties of whipped cream. J. Sci. Food Agric. 2021, 101, 5851–5860. [Google Scholar] [CrossRef]
- Zamani-Ghalehshahi, A.; Farzaneh, P. Effect of hydrocolloid coatings (Basil seed gum, xanthan, and methyl cellulose) on the mass transfer kinetics and quality of fried potato strips. J. Food Sci. 2021, 86, 1215–1227. [Google Scholar] [CrossRef] [PubMed]
- Naji-Tabasi, S.; Razavi, S.M.A.; Mohebbi, M.; Malaekeh-Nikouei, B. New studies on basil (Ocimum bacilicum L.) seed gum: Part I—Fractionation, physicochemical and surface activity characterization. Food Hydrocoll. 2016, 52, 350–358. [Google Scholar] [CrossRef]
- Nazir, S.; Wani, I.A. Functional characterization of basil (Ocimum basilicum L.) seed mucilage. Bioact. Carbohydr. Diet. Fibre 2021, 25, 100261. [Google Scholar] [CrossRef]
- Srikhao, N.; Chirochrapas, K.; Kwansanei, N.; Kasemsiri, P.; Ounkaew, A.; Okhawilai, M.; Likitaporn, C.; Theerakulpisut, S.; Uyama, H. Multi-Responsive Optimization of Novel pH-Sensitive Hydrogel Beads Based on Basil Seed Mucilage, Alginate, and Magnetic Particles. Gels 2022, 8, 274. [Google Scholar] [CrossRef]
- Li, Q.; Renneckar, S. Supramolecular structure characterization of molecularly thin cellulose I nanoparticles. Biomacromolecules 2011, 12, 650–659. [Google Scholar] [CrossRef] [PubMed]
- Chung, C.; Lee, M.; Choe, E.K. Characterization of cotton fabric scouring by FT-IR ATR spectroscopy. Carbohydr. Polym. 2004, 58, 417–420. [Google Scholar] [CrossRef]
- Chiulan, I.; Panaitescu, D.M.; Radu, E.; Vizireanu, S.; Sătulu, V.; Biţă, B.; Gabor, R.A.; Nicolae, C.A.; Raduly, M.; Rădiţoiu, V. Influence of TEMPO oxidation on the properties of ethylene glycol methyl ether acrylate grafted cellulose sponges. Carbohydr. Polym. 2021, 272, 118458. [Google Scholar] [CrossRef]
- Maqsood, H.; Uroos, M.; Muazzam, R.; Naz, S.; Muhammad, N. Extraction of basil seed mucilage using ionic liquid and preparation of AuNps/mucilage nanocomposite for catalytic degradation of dye. Int. J. Biol. Macromol. 2020, 164, 1847–1857. [Google Scholar] [CrossRef]
- Popescu, L.; Cojocari, D.; Lung, I.; Kacso, I.; Ciorîţă, A.; Ghendov-Mosanu, A.; Balan, G.; Pintea, A.; Sturza, R. Effect of Microencapsulated Basil Extract on Cream Cheese Quality and Stability. Molecules 2023, 28, 3305. [Google Scholar] [CrossRef]
- Sukardi, S.; Pulungan, M.H.; Purwaningsih, I.; Sita, P.F. Extraction of phenolic compounds from basil (Ocimum americanum L.) leaves with pretreatment using pulsed electric field (PEF). IOP Conf. Ser. Earth Environ. Sci. 2020, 475, 012056. [Google Scholar] [CrossRef]
- Osano, J.P.; Hosseini-Parvar, S.H.; Matia-Merino, L.; Golding, M. Emulsifying properties of a novel polysaccharide extracted from basil seed (Ocimum bacilicum L.): Effect of polysaccharide and protein content. Food Hydrocoll. 2014, 37, 40–48. [Google Scholar] [CrossRef]
- Rijal, M.S.; Nasir, M.; Purwasasmita, B.S.; Asri, L.A.T.W. Cellulose nanocrystals-microfibrils biocomposite with improved membrane performance. Carbohydr. Polym. Technol. Appl. 2023, 5, 100326. [Google Scholar] [CrossRef]
- González-Ugarte, A.S.; Hafez, I.; Tajvidi, M. Characterization and properties of hybrid foams from nanocellulose and kaolin-microfibrillated cellulose composite. Sci. Rep. 2020, 10, 17459. [Google Scholar] [CrossRef] [PubMed]
- Jeyakumar, N.; Huang, Z.; Balasubramanian, D.; Le, A.T.; Nguyen, X.P.; Pandian, P.L.; Hoang, A.T. Experimental evaluation over the effects of natural antioxidants on oxidation stability of binary biodiesel blend. Int. J. Energy Res. 2022, 46, 20437–20461. [Google Scholar] [CrossRef]
- Qiao, A.; Huang, R.; Wu, J.X.; Qi, W.; Su, R. Anisotropic cellulose nanocrystalline sponge sheets with ultrahigh water fluxes and oil/water selectivity. Carbohydr. Polym. 2023, 312, 120807. [Google Scholar] [CrossRef] [PubMed]
- Mensah, A.; Chen, Y.; Asinyo, B.K.; Howard, E.K.; Narh, C.; Huang, J.; Wei, Q. Bioactive Icariin/β-CD-IC/Bacterial Cellulose with Enhanced Biomedical Potential. Nanomaterials 2021, 11, 387. [Google Scholar] [CrossRef]
- Frone, A.N.; Panaitescu, D.M.; Nicolae, C.A.; Gabor, A.R.; Trusca, R.; Casarica, A.; Stanescu, P.O.; Baciu, D.D.; Salageanu, A. Bacterial cellulose sponges obtained with green cross-linkers for tissue engineering. Mater. Sci. Eng. C 2020, 110, 110740. [Google Scholar] [CrossRef] [PubMed]
- Camparotto, N.G.; de Figueiredo Neves, T.; Mastelaro, V.R.; Prediger, P. Hydrophobization of aerogels based on chitosan, nanocellulose and tannic acid: Improvements on the aerogel features and the adsorption of contaminants in water. Environ. Res. 2023, 220, 115197. [Google Scholar] [CrossRef]
- Mariano, M.; Souza, S.F.; Borges, A.C.; do Nascimento, D.M.; Bernardes, J.S. Tailoring strength of nanocellulose foams by electrostatic complexation. Carbohydr. Polym. 2021, 256, 117547. [Google Scholar] [CrossRef]
- Salahi, M.R.; Razavi, S.M.A.; Mohebbi, M. Physicochemical, Rheological and Structural Properties of Cold-set Emulsion-filled Gels Based on Whey Protein Isolate-basil Seed Gum Mixed Biopolymers. Food Biophys. 2022, 17, 635–649. [Google Scholar] [CrossRef]
- Larki, M.; Enayati, M.H.; Rostamabadi, H. Basil seed gum promotes the electrospinnability of WPI for co-encapsulation of ZnO nanoparticles and curcumin. Carbohydr. Polym. 2022, 296, 119966. [Google Scholar] [CrossRef] [PubMed]
- French, A.D. Idealized powder diffraction patterns for cellulose polymorphs. Cellulose 2014, 21, 885–896. [Google Scholar] [CrossRef]
- Dias, M.C.; Zidanes, U.L.; Mascarenhas, A.R.P.; Setter, C.; Scatolino, M.V.; Martins, M.A.; Mori, F.A.; Belgacem, M.N.; Tonoli, G.H.D.; Ferreira, S.R. Mandacaru cactus as a source of nanofibrillated cellulose for nanopaper production. Int. J. Biol. Macromol. 2023, 235, 123850. [Google Scholar] [CrossRef] [PubMed]
- Wojdyr, M. Fityk: A general-purpose peak fitting program. J. Appl. Crystallogr. 2010, 43, 1126. [Google Scholar] [CrossRef]
- Tarchoun, A.F.; Trache, D.; Klapötke, T.M. Microcrystalline cellulose from Posidonia oceanica brown algae: Extraction and characterization. Int. J. Biol. Macromol. 2019, 138, 837–845. [Google Scholar] [CrossRef]
- El Amri, A.; Ouass, A.; Bensalah, J.; Wardighi, Z.; Bouhassane, F.Z.; Zarrouk, A.; Habsaoui, A.; Rifi, E.-H.; Lebkiri, A. Extraction and characterization of cellulosic nanocrystals from stems of the reed plant large-leaved cattail (Typha latifolia). Mater. Today Proc. 2023, 72 Pt 7, 3609–3616. [Google Scholar] [CrossRef]
- Nazir, S.; Wani, I.A. Development and characterization of an antimicrobial edible film from basil seed (Ocimum basilicum L.) mucilage and sodium alginate. Biocatal. Agric. Biotechnol. 2022, 44, 102450. [Google Scholar] [CrossRef]
- Chiulan, I.; Panaitescu, D.M.; Serafim, A.; Radu, E.R.; Ioniţă, G.; Rădiţoiu, V.; Gabor, A.R.; Nicolae, C.A.; Ghiurea, M.; Baciu, D.D. Sponges from Plasma Treated Cellulose Nanofibers Grafted with Poly(ethylene glycol)methyl Ether Methacrylate. Polymers 2022, 14, 4720. [Google Scholar] [CrossRef]
- Lantto, T.A.; Colucci, M.; Závadová, V.; Hiltunen, R.; Raasmaja, A. Cytotoxicity of curcumin, resveratrol and plant extracts from basil, juniper, laurel and parsley in SH-SY5Y and CV1-P cells. Food Chem. 2009, 117, 405–411. [Google Scholar] [CrossRef]
- Majdi, C.; Pereira, C.; Dias, M.I.; Calhelha, R.C.; Alves, M.J.; Rhourri-Frih, B.; Charrouf, Z.; Barros, L.; Amaral, J.S.; Ferreira, I.C.F.R. Phytochemical Characterization and Bioactive Properties of Cinnamon Basil (Ocimum basilicum cv. ‘Cinnamon’) and Lemon Basil (Ocimum × citriodorum). Antioxidants 2020, 9, 369. [Google Scholar] [CrossRef]
- Perzon, A.; Jørgensen, B.; Ulvskov, P. Sustainable production of cellulose nanofiber gels and paper from sugar beet waste using enzymatic pre-treatment. Carbohydr. Polym. 2020, 230, 115581. [Google Scholar] [CrossRef]

| Sample | T5% (°C) | Ton (°C) | Tmax (°C) | R600 °C (%) |
|---|---|---|---|---|
| NC/BE 4/0 | 219.2 | 315.5 | 335.6 | 2.6 |
| NC/BE 4/2 | 208.8 | 302.4 | 337.3 | 6.2 |
| NC/BE 4/3 | 208.8 | 300.1 | 333.4 | 6.8 |
| NC/BE 4/4 | 210.7 | 298.8 | 332.1 | 8.7 |
| NC/BE/BSM 4/3/1 | 215.3 | 291.7 | 327.7 | 4.7 |
| NC/BE/BSM 4/3/2 | 209.8 | 289.9 | 328.5 | 5.1 |
| Sample | Apparent Density (mg cm−3) | Compression Strength at 50% Strain (kPa) |
|---|---|---|
| NC/BE 4/0 | 17 | 0.95 |
| NC/BE 4/2 | 17 | 1.69 |
| NC/BE 4/3 | 16 | 1.92 |
| NC/BE 4/4 | 18 | 2.78 |
| NC/BE/BSM 4/3/1 | 14 | 2.21 |
| NC/BE/BSM 4/3/2 | 14 | 1.85 |
| Sample | NC Suspension (g) | Basil Extract (g) | Basil Seed Mucilage (g) |
|---|---|---|---|
| NC/BE 4/0 | 50 | - | - |
| NC/BE 4/2 | 50 | 1.875 | - |
| NC/BE 4/3 | 50 | 2.813 | - |
| NC/BE 4/4 | 50 | 3.750 | - |
| NC/BE/BSM 4/3/1 | 50 | 2.813 | 12.5 |
| NC/BE/BSM 4/3/2 | 50 | 2.813 | 25.0 |
Disclaimer/Publisher’s Note: The statements, opinions and data contained in all publications are solely those of the individual author(s) and contributor(s) and not of MDPI and/or the editor(s). MDPI and/or the editor(s) disclaim responsibility for any injury to people or property resulting from any ideas, methods, instructions or products referred to in the content. |
© 2023 by the authors. Licensee MDPI, Basel, Switzerland. This article is an open access article distributed under the terms and conditions of the Creative Commons Attribution (CC BY) license (https://creativecommons.org/licenses/by/4.0/).
Share and Cite
Oprică, G.M.; Panaitescu, D.M.; Usurelu, C.D.; Vlăsceanu, G.M.; Stanescu, P.O.; Lixandru, B.E.; Vasile, V.; Gabor, A.R.; Nicolae, C.-A.; Ghiurea, M.; et al. Nanocellulose Sponges Containing Antibacterial Basil Extract. Int. J. Mol. Sci. 2023, 24, 11871. https://doi.org/10.3390/ijms241411871
Oprică GM, Panaitescu DM, Usurelu CD, Vlăsceanu GM, Stanescu PO, Lixandru BE, Vasile V, Gabor AR, Nicolae C-A, Ghiurea M, et al. Nanocellulose Sponges Containing Antibacterial Basil Extract. International Journal of Molecular Sciences. 2023; 24(14):11871. https://doi.org/10.3390/ijms241411871
Chicago/Turabian StyleOprică, Gabriela Mădălina, Denis Mihaela Panaitescu, Catalina Diana Usurelu, George Mihai Vlăsceanu, Paul Octavian Stanescu, Brandusa Elena Lixandru, Valentin Vasile, Augusta Raluca Gabor, Cristian-Andi Nicolae, Marius Ghiurea, and et al. 2023. "Nanocellulose Sponges Containing Antibacterial Basil Extract" International Journal of Molecular Sciences 24, no. 14: 11871. https://doi.org/10.3390/ijms241411871
APA StyleOprică, G. M., Panaitescu, D. M., Usurelu, C. D., Vlăsceanu, G. M., Stanescu, P. O., Lixandru, B. E., Vasile, V., Gabor, A. R., Nicolae, C.-A., Ghiurea, M., & Frone, A. N. (2023). Nanocellulose Sponges Containing Antibacterial Basil Extract. International Journal of Molecular Sciences, 24(14), 11871. https://doi.org/10.3390/ijms241411871

